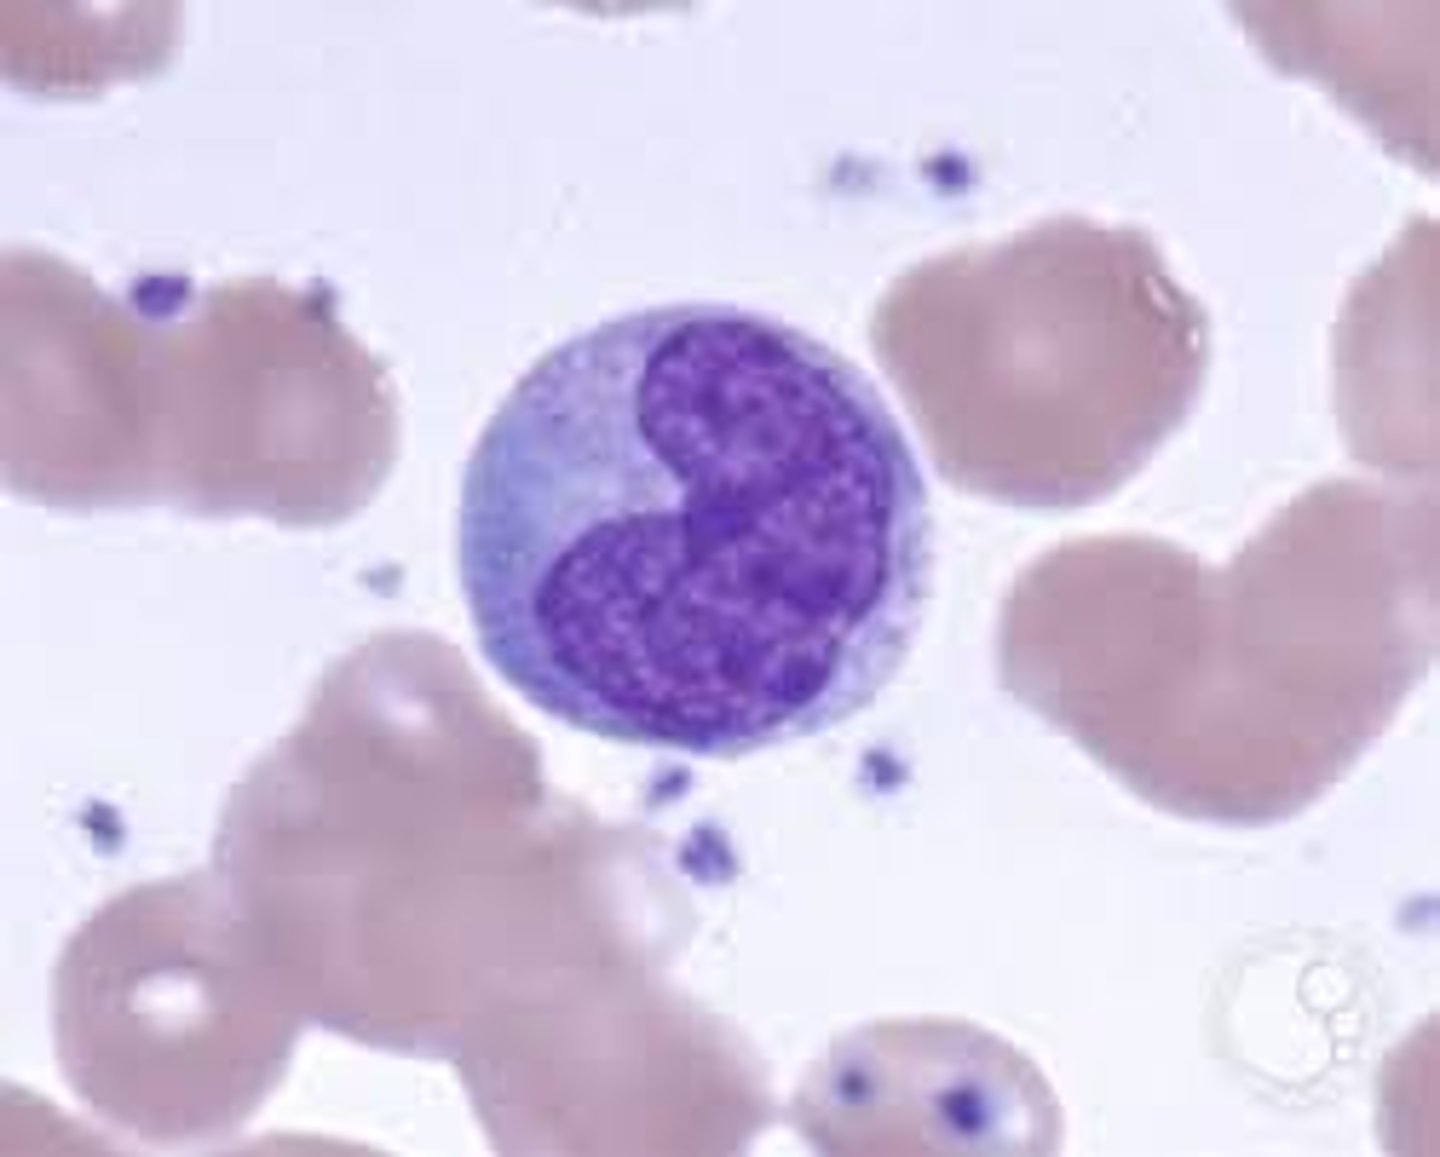
<p>Agranular</p><p>Largest WBC</p><p>Kidney-shaped nucleus</p><p>Can leave blood and enter the surrounding tissue (becoming macrophages) </p><p>produced in the bone marrow</p><p>Viral or fungal infections</p>

NURS 210/211 Exam 3
1/281
There's no tags or description
Looks like no tags are added yet.
Name | Mastery | Learn | Test | Matching | Spaced | Call with Kai |
|---|
No analytics yet
Send a link to your students to track their progress
282 Terms
Blood is a liquid connective tissue consisting of
cells surrounded by a liquid matrix (plasma)
Composition of blood post centrifuge (%)
Blood plasma (55%)
Red blood cells (45%)
Buffy coat in the middle composed of white blood cells and platelets

What is the name of the three layers formed from centrifuged blood
Erythrocytes on the bottom (~45% of the whole blood)
Hematocrit: percent of blood volume that is RBCs
◼ Normal values:
❑ Males: 47% ± 5%
❑ Females: 42% ± 5%
❑ WBCs and platelets in Buffy coat (< 1%)
◼ Thin, whitish layer between RBCs and plasma
layers
Plasma on top (~55%)

The cellular components (formed elements) of blood
include red blood cells, white blood cells, and platelets
The plasma portion of blood consists of...
water (91.5%)
proteins (7%)
-Albumins (54%)
-Globulins (38%), immunoglobulin, aka "Antibodies."
-Fibrinogen (7%) blood clot factors
-all others (1%)
and other solutes (1.5%)
Formed elements consist of
red blood cells 4.8-5.4 million
platelets 150,000-400,000
white blood cells 5,000-10,000
-Neutrophils (60-70%)
-Lymphocytes (20-25%)
-Monocytes (3-8%)
-Eosinophils (2-4%)
-Basophils (.5-1%)

Blood transports...
oxygen, carbon dioxide, nutrients, hormones, heat, and waste products
Blood regulates...
homeostasis of all body fluids, pH, body temperature, and water content of cells
Blood protects...
against excessive loss by clotting, and uses white blood cells to protect against infections
The process of producing blood cells is
hemopoiesis (hematopoiesis)

What differentiates into each of the different types of blood cells
Pluripotent stem cells
Colony-stimulating factors (CSFs) are...
secreted glycoproteins that bind to receptor proteins on the
surfaces of hemopoietic stem cells, causing the cells to
proliferate and differentiate into a specific kind of blood
cell
Administration of exogenous colony-stimulating factors stimulates...
bone marrow to produce more of the particular white blood cells
Red blood cells (erythrocytes) contain the protein
hemoglobin that is used to carry oxygen to all cells and
to carry some carbon dioxide to the lungs
Each hemoglobin molecule contains (how many _____Ions) which allows each molecule to bind four oxygen molecules
4 iron ions
Red blood cells have no nucleus or other organelles and
are
biconcave discs
❑ This allows them to carry oxygen more efficiently
RBCs contain plasma membrane protein___which proveds flexibilyt to change shape
Spectrin
Hemoglobin is involved in regulating blood flow and
blood pressure via the release of____
Nitric Oxide (NO)
Nitric oxide causes_____, which improves blood flow and enhances oxygen delivery
vasodilation
Red blood cells also contain______, which catalyzes the conversion of carbon dioxide and water to carbonic acid
carbonic anhydrase
Red blood cells live for only about_____
120 days
Dead cells are removed from the circulation by the
spleen and liver
Erythropoiesis
(production of red blood cells) begins in the red bone marrow
Erythropoietin, a hormone released by the kidneys in response to______(lowered oxygen concentration) stimulates differentiation of hematopoietic stem cells into erythrocytes
hypoxia
Reticulocytes
(immature red blood cells) enter the circulation and mature in 1 to 2 days
Some athletes abuse artificial EPO (erythropoietin)
Use of EPO increases hematocrit, which allows athletes to increase stamina and performance (thicker blood viscosity = more oxygen)
EPO consequences
❑ EPO can increase hematocrit from 45% up to even
65%, with dehydration concentrating the blood even more
❑ Blood becomes like sludge and can cause clotting,
stroke, or heart failure
Anemia:
blood has abnormally low O2-carrying capacity due to a low count of RBC and decreased hemoglobin
Sickle cell disease
It is a genetic anemia. The RBC in this disease contains hemoglobin-S (Hb-S), which causes red blood cells to bend into a sickle shape when they release oxygen to the interstitial fluid.
Iron-deficiency
Anemia is the most common type, caused by blood loss, but also by low iron intake or impaired absorption
Erythropoietin (EPO) was first isolated from the urine of
anemic patients who had high circulating levels of the
hormone. Despite the presence of the hormone that
stimulates red cell production, however, these patients
were unable to produce adequate amounts of
hemoglobin or red cells. Give some possible reasons
why the patients' own EPO was unable to correct their
anemia.
Missing materials (iron, B12, folate)
Bone marrow not responding (damage/disease)
Chronic inflammation blocking effect
Defective RBC production
Ongoing blood loss or hemolysis
EPO resistance
Sue is fatigued, and some blood tests have been done. Her
results include Hct 40%; Hgb 8g/dL; RBC 3.7million; and
platelets 175,000. The nurse should interpret Sue's
blood work as indicative of:
This is anemia — specifically a low hemoglobin and low RBC count
White blood cells (leukocytes) contain a
nucleus and organelles, but no hemoglobin
Leukocytes (white blood cells) are classified as:
Granular (containing vesicles that appear when the cells are stained)
◼ Granular leukocytes: neutrophils, eosinophils, basophils
❑ Agranular (containing no granules)
◼ Agranular leukocytes: lymphocytes, monocytes
Neutrophil (60-70%)
Granular
The most abundant type of white blood cell acts as the immune system's first line of defense against bacterial infections and acute inflammation. Phagocytes

Lymphocyte (20-25%)
Agranular
(B cells, T cells, NK cells) produces antibodies
-Viral infections, some leukemias, and infectious mononucleosis
-"lymph" associated lymphoid tissues (lymph nodes, spleen, etc.)

Monocytes (3-8%)
Agranular
Largest WBC
Kidney-shaped nucleus
Can leave blood and enter the surrounding tissue (becoming macrophages)
produced in the bone marrow
Viral or fungal infections
Eosinophils (2-4%)
Granular
Elevated in parasitic infection
Increase during allergic reactions
Stains orange/red

Basophils (.5-1%)
Granular
secretes histamine
promote vasodilation and enhance the migration of leukocytes to inflammatory sites

White blood cells may live for several months or years; their main function is to
combat invading microbes
During an invasion, many white blood cells are able to
leave the bloodstream and collect at sites of invasion
❑ The process is called emigration (diapedesis)
An elevation in the white blood count usually indicates an
infection or inflammation
Meghan thinks she has an abscessed tooth (a bacterial
infection). If she does, what type of white blood cell
would you expect to see in elevated numbers in a
differential count?
Neutrophil
________, ________, and ________ are called
granulocytes because ________.
Neutrophil, Basophil, and Eosinophil
-contain granuales
What is a differential white cell count, and when is it used?
% of specific WBCs
Megakaryocytes
In red bone marrow, splinter into 2000-3000 fragments to create the platelets that contain many vesicles but no nucleus
Under the influence of the hormone______, hemopoietic stem cells differentiate into megakaryocytes and form platelets
thrombopoietin
Platelets are used to
Clot the blood
Hemostasis is a sequence of responses to stop
Bleeding
The process of Hemostasis involves
❑ Vascular spasm
❑ Platelet plug formation
❑ Blood clotting (coagulation)
When activated, platelets swell, become spiked, sticky
and release chemical messengers:
❑ ADP causes more platelets to stick
❑ Serotonin and thromboxane A2 enhance vascular spasm and platelet aggregation
Positive feedback cycle:
As more platelets stick, they release more chemicals, which cause more platelets to stick
Blood clotting can be activated in one of 2 ways:
❑ Extrinsic pathway
❑ Intrinsic pathway
Intrinsic pathway
clotting factors are activated within the blood
Extrinsic pathway
clotting factors are activated in tissues located outside blood
❑ Triggered by exposure to tissue factor (TF)
Both of these pathways lead to the formation of_____and, from there, the common pathway continues
Prothrombinase
Phase 2: Pathway to thrombin
Prothrombinase catalyzes the transformation of prothrombin to the active enzyme thrombin
Phase 3: Common pathway to the fibrin mesh
Thrombin converts soluble fibrinogen to fibrin
◼ Fibrin strands form the structural basis of the clot
◼ Fibrin causes plasma to become a gel-like trap, catching formed elements
Once the clot forms
It retracts (tightens) to pull the edges of the damaged vessel together
What is fibrinolysis?
A process whereby clots are removed after repair is completed.
What is plasminogen?
A plasma protein that is trapped in a clot.
What is plasmin?
A fibrin-digesting enzyme.
What converts plasminogen to plasmin?
Plasminogen is converted to plasmin during fibrinolysis via tPA (Tissue Plasminogen Activator)
Thrombus
A clot that develops and persists in an unbroken blood vessel
◼ May block circulation, leading to tissue death
Embolus
A thrombus freely floating in the bloodstream
◼ Embolism: embolus obstructing a vessel. Example:
pulmonary or cerebral embol
Bleeding disorders. Thrombocytopenia:
deficient number of circulating platelets, cause spontaneous hemorrhage
Blood Groups and Blood Types
◼ At least 100 known blood groups
◼ Groups: ABO and Rh: cause the most vigorous transfusion reactions
Rh blood groups
❑ Named Rh agglutinogens (Rh factors)
❑ Rh+ indicates the presence of the D antigen
❑ 85% Americans are Rh+
Rh positive (+)
Do have D antigens present on surface of RBCs
Rh negative (-)
Do not have D antigens present
❑ Anti−Rh antibodies form if Rh- individual receives
Rh+ blood, or Rh- mom is carrying Rh+ fetus
Blood type is determined by ______--molecules
on the surface of RBCs.
Antigens
Antigens stimulate production of:
Antibodies -- proteins in plasma that attack foreign antigens
resulting in agglutination(clumping) and hemolysis (rupture) of RBCs
Blood plasma usually contains __________
that react with A or B antigens
antibodies (agglutinins)
IMPORTANT
◼ An individual will not have agglutinins against his or her
own blood type
◼ Mismatched transfused blood is perceived as foreign
and may be agglutinated and destroyed
◼ Potentially fatal reaction
Blood Types

A drop of blood is mixed with an antiserum that will
agglutinate blood cells that possess agglutinogens that
react with it

Why is O- universal donor
no antigens
Why is AB the universal recipient?
No A or B antibodies
True or False: Type A blood would have anti-A antibodies in the plasma
False (type B would)
If a person has AB type blood, which of the ABO blood types can they receive as a transfusion?
All of them are "universal recipients" with no antibodies
Hemolytic Disease of the Newborn
❑ If the baby is Rh+ and the mother is Rh-, she will
develop antibodies to the Rh factor
❑ During next pregnancy with an Rh+ baby, when
mother transfers antibodies to the fetus (a normal
occurrence), transferred anti Rh antibodies will
attack some of the fetal red blood cells causing
agglutination and hemolysis- erythroblastosis fetalis
(hemolytic disease of the newborn)
❑ *Prevention- RhoGam injection: inhibit anti-Rh
antibodies*
Bill wants to determine his blood type, so he takes a few
drops of blood from a puncture wound in his finger and
mixes it with various antisera. His blood cells agglutinate
when mixed with the anti-A sera but not with the anti-B
or anti-D sera. What does this mean?
◼ A) Bill could receive type B-negative blood in a
transfusion.
◼ B) Bill could donate blood to an individual with type O
blood.
◼ C) Bill is Rh positive.
◼ D) Bill's plasma contains B antibodies.
◼ D) Bill's plasma contains B antibodies.
Bill's blood type is A negative.
John and Laura are expecting their first child. John is Rh- and Laura is Rh+. Do they have to worry about Rh compatibility?
No, only when Laura is negative and John is positive
The heart is located in the
mediastinum
The heart is enclosed and held in place by the
percardium
The pericardium consists of an
outer fibrous pericardium and an inner serous pericardium
The serous pericardium has 2 layers:
1. Visceral (innermost)
2. Parietal (outermost)
The wall of the heart has 3 layers
1. Epicardium
2. Myocardium
3. Endocardium
Gross Anatomy of the Heart

Gross anatomy of the heart

The right atrium receives blood from the
superior and inferior vena cava and the coronary sinus
The right ventricle receives blood from
The right atrium and sends blood to the lungs via the pulmonary trunk
The left atrium receives oxygenated blood from the
pulmonary veins
The left ventricle receives blood from the left atrium and sends blood
All over the body via the Aorta
Note that the wall of the left ventricle is much thicker than that of the right ventricle - why?
It must generate significantly higher pressure to pump blood throughout the entire body
Heart Valves
◼ Ensure unidirectional blood flow through heart
◼ Open and close in response to pressure changes
Two major types of valves: Atrioventricular valves (right and left)
located between atria and ventricles
◼ Prevent backflow from the ventricles into the atria
Two major types of valves: Semilunar valves (right and left)
located between ventricles and major arteries
◼ Prevent back flow from the arteries into the ventricles
Two atrioventricular (AV) valves: Tricuspid
(right AV valve): Made up of three cusps and lies between the right atrium and ventricle

Two atrioventricular (AV) valves: Mitral (bicuspid) valve
(left AV valve, bicuspid valve): made up of two cusps and lies between the left atrium and the ventricle
